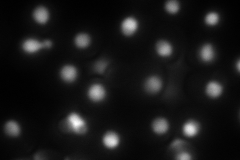
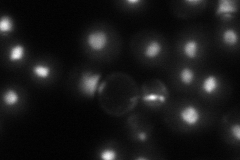

View description
Histone variant H2AZ, exchanged for histone H2A in nucleosomes by the SWR1 complex; involved in transcriptional regulation through prevention of the spread of silent heterochromatin
Localization:
Intensity:
Fold change:
Significance:
-
C’ GFP library in SD

nucleus120.4 -
N' NOP1pr-GFP in SD

nucleus197.604 -
N' TEF2pr-mCherry in SD
nucleus138.504 -
N' NATIVEpr-GFP in SD
nucleus80.1296 -
N' TEF2pr-VC and Cyto-VN in SD

nucleus53.3354 -
C’ GFP library in SD+DTT

nucleus126.011.04No -
C’ GFP library in SD+H2O2

nucleus70.180.58Yes -
C’ GFP library in Starvation Media

nucleus143.231.18No -
C’ GFP library on the background of Pup2-DaMP

nucleus -
C’ GFP library on the background of CCT mutant

nucleus80.94680.67228No
